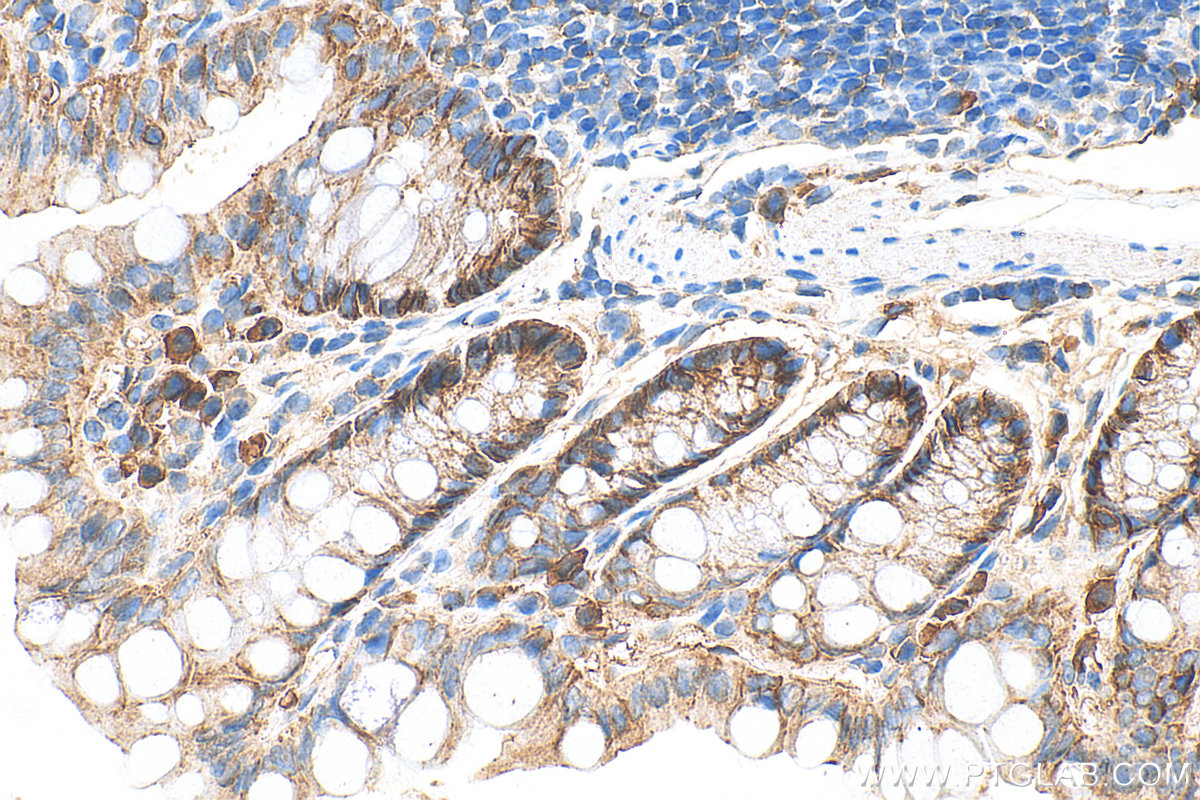

验证数据展示
经过测试的应用
| Positive WB detected in | HUVEC cells, A431 cells, mouse kidney tissue, Caco-2 cells, mouse brain tissue, mouse colon tissue, rat colon tissue, rat brain tissue |
| Positive IP detected in | HUVEC cells |
| Positive IHC detected in | human colon tissue, human breast cancer tissue, human kidney tissue, mouse colon tissue Note: suggested antigen retrieval with TE buffer pH 9.0; (*) Alternatively, antigen retrieval may be performed with citrate buffer pH 6.0 |
| Positive IF-Fro detected in | mouse brain tissue |
| Positive IF/ICC detected in | Caco-2 cells, MCF-7 cells |
| Positive FC (Intra) detected in | MCF-7 cells |
推荐稀释比
| 应用 | 推荐稀释比 |
|---|---|
| Western Blot (WB) | WB : 1:5000-1:50000 |
| Immunoprecipitation (IP) | IP : 0.5-4.0 ug for 1.0-3.0 mg of total protein lysate |
| Immunohistochemistry (IHC) | IHC : 1:1000-1:10000 |
| Immunofluorescence (IF)-FRO | IF-FRO : 1:50-1:500 |
| Immunofluorescence (IF)/ICC | IF/ICC : 1:250-1:1000 |
| Flow Cytometry (FC) (INTRA) | FC (INTRA) : 0.25 ug per 10^6 cells in a 100 µl suspension |
| It is recommended that this reagent should be titrated in each testing system to obtain optimal results. | |
| Sample-dependent, Check data in validation data gallery. | |
产品信息
27260-1-AP targets Occludin in WB, IHC, IF/ICC, IF-Fro, FC (Intra), IP, ELISA applications and shows reactivity with human, mouse, rat samples.
| 经测试应用 | WB, IHC, IF/ICC, IF-Fro, FC (Intra), IP, ELISA Application Description |
| 文献引用应用 | WB, IHC, IF, IP |
| 经测试反应性 | human, mouse, rat |
| 文献引用反应性 | human, mouse, rat, pig, rabbit, canine, chicken, bovine, goat, duck |
| 免疫原 |
CatNo: Ag26173 Product name: Recombinant human Occludin protein Source: e coli.-derived, PGEX-4T Tag: GST Domain: 360-522 aa of BC029886 Sequence: VDDFRQPRYSSGGNFETPSKRAPAKGRAGRSKRTEQDHYETDYTTGGESCDELEEDWIREYPPITSDQQRQLYKRNFDTGLQEYKSLQSELDEINKELSRLDKELDDYREESEEYMAAADEYNRLKQVKGSADYKSKKNHCKQLKSKLSHIKKMVGDYDRQKT 种属同源性预测 |
| 宿主/亚型 | Rabbit / IgG |
| 抗体类别 | Polyclonal |
| 产品类型 | Antibody |
| 全称 | occludin |
| 别名 | OCLN |
| 计算分子量 | 522 aa, 59 kDa |
| 观测分子量 | 59 kDa, 53 kDa, 32 kDa, 23-25 kDa |
| GenBank蛋白编号 | BC029886 |
| 基因名称 | Occludin |
| Gene ID (NCBI) | 4950 |
| RRID | AB_2880820 |
| 偶联类型 | Unconjugated |
| 形式 | Liquid |
| 纯化方式 | Antigen affinity purification |
| UNIPROT ID | Q16625 |
| 储存缓冲液 | PBS with 0.02% sodium azide and 50% glycerol, pH 7.3. |
| 储存条件 | Store at -20°C. Stable for one year after shipment. Aliquoting is unnecessary for -20oC storage. |
背景介绍
Occludin is an integral membrane protein located at the tight junction. It is a tetraspanin protein with four transmembrane domains, intracellular N and C termini, and two extracellular loops. Occludin plays a role in the formation and regulation of the tight junction paracellular permeability barrier. Occludin can exist in different isoforms, owing to modifications at the posttranscriptional and posttranslational levels, the monomeric occludin migrates as 53-65 kDa on SDS-PAGE (PMID: 22083955; 19457074).
实验方案
| Product Specific Protocols | |
|---|---|
| FC protocol for Occludin antibody 27260-1-AP | Download protocol |
| IF protocol for Occludin antibody 27260-1-AP | Download protocol |
| IHC protocol for Occludin antibody 27260-1-AP | Download protocol |
| IP protocol for Occludin antibody 27260-1-AP | Download protocol |
| WB protocol for Occludin antibody 27260-1-AP | Download protocol |
| Standard Protocols | |
|---|---|
| Click here to view our Standard Protocols |
发表文章
| Species | Application | Title |
|---|---|---|
Cell Metab Acetate enables metabolic fitness and cognitive performance during sleep disruption | ||
J Clin Invest A20 regulates lymphocyte adhesion in murine neuroinflammation by restricting endothelial ICOSL expression in the CNS | ||
Microbiome Arula-7 powder improves diarrhea and intestinal epithelial tight junction function associated with its regulation of intestinal flora in calves infected with pathogenic Escherichia coli O1 | ||
Microbiome Zearalenone disturbs the reproductive-immune axis in pigs: the role of gut microbial metabolites | ||
Adv Sci (Weinh) Plasma-Activated Solutions Mitigates DSS-Induced Colitis via Restoring Redox Homeostasis and Reversing Microbiota Dysbiosis | ||
Neuron C5aR1+ microglia exacerbate neuroinflammation and cerebral edema in acute brain injury |